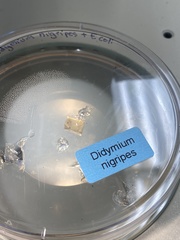
Didymium nigripes

Didymium nigripes: taxon details and analytics
- Domain
- Kingdom
- Protozoa
- Phylum
- Mycetozoa
- Class
- Myxomycetes
- Order
- Physarales
- Family
- Didymiaceae
- Genus
- Didymium
- Species
- Didymium nigripes
- Scientific Name
- Didymium nigripes
Summary description from Wikipedia:
Didymium nigripes in languages:
- Czech
- dvojblanka černonohá
- Dutch
- Zwartstelig kristalkopje
- Finnish
- kadevitinen
- Russian
- Дидимиум черноногий
Images from inaturalist.org observations:
We recommend you sign up for this excellent, free service.
Parent Taxon
Sibling Taxa
- Didymium anellus
- Didymium annellus
- Didymium annulisporum
- Didymium bahiense
- Didymium clavodecus
- Didymium clavus
- Didymium comatum
- Didymium crustaceum
- Didymium difforme
- Didymium dubium
- Didymium eximium
- Didymium floccoides
- Didymium floccosum
- Didymium intermedium
- Didymium iridis
- Didymium karstensii
- Didymium laxifilum
- Didymium leptotrichum
- Didymium listeri
- Didymium megalosporum
- Didymium melanospermum
- Didymium minus
- Didymium mucilago
- Didymium muscorum
- Didymium nigripes
- Didymium nivicola
- Didymium obducens
- Didymium ochroideum
- Didymium pertusum
- Didymium projectile
- Didymium proximum
- Didymium quitense
- Didymium serpula
- Didymium simlense
- Didymium squamulosum
- Didymium trachysporum
- Didymium vaccinum
- Didymium verrucisporum